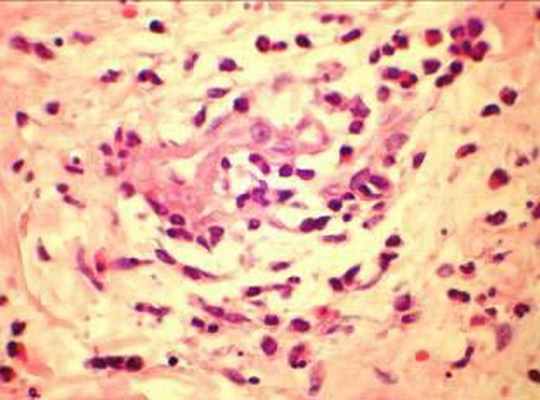
биопсия кожно-мышечного лоскута

ЭхоКГ при гиперэозинофильном синдроме
Добавил пользователь Alex Обновлено: 22.11.2025
J. Churg, L. Strauss (1951) дали подробное описание 13 наблюдений больных, имевших сочетание тяжелой бронхиальной астмы с гиперэозинофилией и поражением других органов. В 9 из 10 аутопсий авторы отметили воспалительные изменения, свойственные узелковому периартерииту (окклюзии артерий во многих органах), а также участки гранулематозного поражения с эозинофильной инфильтрацией и фибриноидным поражением соединительной ткани и сосудов. Авторы трактовали эту тяжелую патологию с неблагоприятным прогнозом, как злокачественный ангиит. В современных классификациях синдром, описанный Churg, Strauss и названный их именами, рассматривается, как аллергический ангиит. Распространенность синдрома Сhurg-Strauss составляет 1-3 случая на 1 000 000 населения [1]. В литературе представлены противоречивые данные о частоте заболевания мужчин и женщин: соотношение колеблется от 3:1 до 1:2 [2, 3]. В связи с полиморфизмом клинической картины болезни пациенты зачастую первоначально обращаются за медицинской помощью не к ревматологам, а к представителям других специальностей. Редкость патологии создает дополнительные трудности своевременной диагностики заболевания. Примером сложности диагностики может служить следующее наблюдение.
Больной С., 33 г., по профессии электромонтажник, поступил в НМХЦ им. Н.И. Пирогова 5 февраля 2007 г. с жалобами на одышку при незначительной физической нагрузке, кашель с трудноотделяемой мокротой слизистого характера, общую слабость, похудание на 10 кг, субфебрильную температуру тела. С 2000 г. у пациента диагностировали хронический ринит, синусит, полипоз носа. Для купирования затрудненного носового дыхания последние 3 года применял кортикостероидный назальный спрей. В связи с возникновением приступов удушья 2006 г. в НИИ аллергологии и иммунологии диагностирована бронхиальная астма среднетяжелого течения. Назначена терапия симбикортом с положительным эффектом. Ухудшение состояния с декабря 2006, когда появились субфебрильная температура тела, приступы затрудненного дыхания, одышка при физической нагрузке, снижение аппетита. При КТ органов грудной клетки, выполненной амбулаторно 25.01.07г.: лимфаденопатия средостения (лимфоузлы до 2-2,5 см) с образованием конгломерата размером 38 х 40 х 50 мм (рис. 1), снижение прозрачности легочной ткани по типу «матового стекла» (рис. 2а), диффузное уплотнение интерстициальной ткани (рис. 2б), двусторонний гидроторакс. Заподозрена опухоль переднего средостения в связи, с чем пациент госпитализирован для морфологической верификации диагноза.
![]() | ![]() |
| Рис. 1. КТ грудной клетки: а - в области вилочковой железы образование размером 38х40х50мм, б - увеличение лимфатических узлов средостения до 20-25 мм. | |
![]() | ![]() |
![]() | ![]() |
| Рис. 2. КТ грудной клетки: а - снижение прозрачности по типу “матового стекла“, б - диффузное уплотнение интерстициальной ткани. | |
| Рис. 3. на ЭКГ зубцы QS отведениях V1-V3. | |
Рентгенография грудной клетки 11.02.07: усиление легочного рисунка с преобладанием застойных изменений с обеих сторон, жидкость в задних синусах, корни расширены, сердце увеличено за счет левого желудочка. При исследовании плевральной жидкости уд. вес 1010, цвет желтый, белок 18 г/л, р. Ривальта слабо положительная, эозинофилия до 77%. Учитывая выраженную эозинофилию дифференциальная диагностика проводилась между гиперэозинофильным синдромом Леффлера и системным некротизирующим васкулитом Чарга-Стросса. С целью уточнения диагноза выполнена биопсия кожно-мышечного лоскута: периваскулярные инфильтраты с большим количеством эозинофилов, поражением артериол с некрозом стенок (рис. 4), картина продуктивного воспаления (рис. 5). При исследовании антинейтрофильных цитоплазматических антител получен отрицательный результат.
![]() Рис. 4. Поражение артрериол с некрозом стенки | ![]() Рис. 5. продуктивное воспаление сосуда, очаговая клеточная инфильтрация эозинофилами |
Анамнестические указания на аллергический риносинусит, полипоз носа, а в последующем и бронхиальную астму, поражение легких (диффузное уплотнение интерстициальной ткани и снижение прозрачности по типу “мaтового стекла” по данным КТ), сердца (диффузные изменения миокарда левого желудочка со снижением сократительной способности миокарда без четких признаков очагово-рубцовых изменений), кожи по типу сосудистой пурпуры и ливедо, гиперэозинофилии периферической крови и плеврального выпота, гистологических признаков продуктивно-некротического васкулита с эозинофильной инфильтрацией кожи и мышц позволили диагностировать системный гранулематозный васкулит – синдром Чарга-Стросса. После проведения биопсии в связи с тяжестью состояния больного назначена терапия солумедролом 250 мг в/в. После гистологического подтверждения диагноза проводилась комбинированная иммуносупрессивная терапия метипредом 40 мг в день внутрь и азатиоприном 100 мг в день. Температура стойко нормализовалась на третий день комбинированной терапии.
В течение недели прошла одышка, уменьшилась тахикардия, над легкими перестали выслушиваться хрипы, подверглись обратному развитию проявления геморрагического васкулита и ливедо. Однократно проведена плевральная пункция с удалением 700 мл выпота соломенно-желтого цвета. При контрольной КТ органов грудной клетки через неделю лечения лимфаденопатия средостения и изменения легочной ткани по типу “мaтового стекла” не определялись (рис. 6). В стационаре прибавил в весе 5 кг. Клинический анализ крови нормализовался с марта 2007 г.
![]() | ![]() |
| Рис. 6. КТ через месяц лечения: отсутствуют изменения в средостении и легочной ткани | |
После выписки из стационара самочувствие удовлетворительное, в апреле приступил к работе. В мае 2007 доза метипреда снижена до 24 мг/сут, азатиоприн продолжал принимать в прежней дозе. В июне 2007 г. определялись умереннные проявления сердечной недостаточности: легкая пастозность голеней, тахикардия. На ЭКГ и ЭхоКГ сохранялись прежние изменения. К лечению добавлен бисопролол. Особенностью данного клинического наблюдения явилось увеличение лимфатических узлов средостения в дебюте, являющееся редким проявлением синдрома Чарг-Стросса, и направившее диагностический поиск по ложному пути. Наличие конгломерата узлов в проекции вилочковой железы у пациента с субфебрильной температурой тела требовал проведения дифференциальной диагностики с лимфопролиферативными заболеваниями и злокачественной опухолью. Однако полисиндромность поражения в сочетании с большой эозинофилией крови позволили усомниться в опухолевой природе болезни и заподозрить системный васкулит, доказанный в последующем. На фоне комбинированной терапии лимфоаденопатия средостения быстро подверглась обратному развитию. В клинической картине заболевания превалировали проявления нарастающей сердечной и дыхательной недостаточности.
По данным Центра васкулитов Джона Хопкинса наиболее грозными висцеральными проявлениями являются быстроразвивающаяся сердечная недостаточность (наблюдавшаяся у нашего пациента), приводящая в 50-80% случаев к летальному исходу несмотря на активную кортикостероидную терапию; инфаркт миокарда вследствие коронариита; геморрагический или ишемический инсульт в 3-7% случаев вследствие церебрального васкулита; поражение желудочно-кишечного тракта с образованием язв желудка, кишечника, кровотечением, перфорацией язв, перитонитом – в 37-62% случаях. В нашем наблюдении отсутствовало поражение почек, нервной системы и желудочно-кишечного тракта, являющееся типичным проявлениям болезни. Антинейтрофильные цитоплазматические антитела не были повышены. При синдроме Чарга-Стросса они выявляются в 67-80% случаев, реже чем при гранулематозе Вегенера, микроскопическом полиартериите [4]. Поражение сердца, легочные инфильтраты и плеврит чаще наблюдаются у пациентов с отсутствием антител к цитоплазме нейтрофилов, что мы и констатировали у нашего больного. Своевременная диагностика, адекватное, максимально быстрое начало лечения позволяют достигать ремиссии при столь грозном заболевании более чем у 80% пациентов. Развитие хронической сердечной недостаточности требует проведения дополнительной терапии в соответствии с рекомендациями Европейского общества кардиологов (2005).
Литература
© 2022 ФГБУ «НМХЦ им. Н.И. Пирогова» Минздрава России. Использование материалов сайта полностью или частично без письменного разрешения строго запрещено.
Гиперэозинофильный синдром
Гиперэозинофильный синдром является состоянием, которое характеризуется эозинофилией периферической крови с проявлениями поражения или дисфункции систем органов, обусловленных непосредственно эозинофилией у пациентов без паразитарных, аллергических или других вторичных причин эозинофилии Важные расстройства и методы лечения, связанные с эозинофилией . Симптомы разнообразны и зависят от того, дисфункция каких органов имеет место. Диагноз включает исключение других причин эозинофилии и дополнительно – исследование костного мозга и цитогенетические анализы. Лечение может включать в себя преднизолон и иногда иматиниб, однако его схема зависит от конкретного подтипа гиперэозинофильного синдрома.
Гиперэозинофильный синдром ранее считался идиопатическим, молекулярное исследование показало, что во многих случаях наблюдаются специфические клональные нарушения. Одним ограничением традиционного определения является то, что оно не включает пациентов с наличием некоторых аналогичных патологий (например, хромосомных дефектов), которые являются широко известными причинами гиперэозинофильного синдрома, но не соответствуют его традиционным диагностическим критериям относительно степени или продолжительности эозинофилии. Еще одним ограничением является то, что некоторым больным с эозинофилией и повреждениями органов, которые характеризуют гиперэозинофильный синдром, необходимо начинать лечение ранее 6 месяцев, необходимых для подтверждения традиционных диагностических критериев. Эозинофилия любой этиологии может вызывать такие же виды повреждения тканей.
Клональные гиперэозинофильные синдромы
Выделяют два основных подтипа клонального гиперэозинофильного синдрома (см. таблицу Клональные гиперэозинофильные синдромы Подтипы гиперэозинофильного синдрома ):
Миелопролиферативный вариант часто связан с небольшой интерстициальной делецией хромосомы 4 на участке CHIC2 которое вызывает связанный с FIP1L1/PDGFRA гибридный ген (имеющий тирозинкиназную активность, которая способна трансформировать гематопоэтические клетки). У больных часто наблюдается:
Повышенный уровень витамина B12
Гипогранулярные или вакуолизированные эозинофилы
У пациентов с миелопролиферативным подтипом часто развивается эндомиокардиальный фиброз и редко возникает острая миелоидная лейкемия Острый миелолейкоз (ОМЛ) При остром миелолейкозе (ОМЛ) злокачественная трансформация и неконтролируемая пролиферация аномально дифференцированных, долго живущих клеток-предшественниц миелоидного ряда вызывает появление. Прочитайте дополнительные сведения . Пациенты, имеющие связанный с FIP1L1/PDGFRA гибридный ген, чаще являются мужчинами и могут быть восприимчивы к приему низких доз иматиниба (ингибитор тирозинокназы).
Небольшая часть пациентов с миелопролиферативным вариантом гиперэозинофильного синдрома имеет цитогенетические изменения, которые затрагивают бета-рецептор тромбоцитарного фактор роста (PDGFRB) и может также отвечать на применение ингибиторов тирозин-киназы, таких как иматиниб ( 1 Общие справочные материалы Гиперэозинофильный синдром является состоянием, которое характеризуется эозинофилией периферической крови с проявлениями поражения или дисфункции систем органов, обусловленных непосредственно. Прочитайте дополнительные сведения ). К другим цитогенетическим аномалиям относится реаранжировка гена рецепторов 1 фактора роста фибробластов (FGFR1) или гена янус-киназы-2 (PCM1-JAK2).
У некоторых пациентов наблюдается хронический эозинофильный лейкоз, когда количество бластных клеток при исследовании костного мозга увеличено, но не более чем на 20%.
Лимфопролиферативный вариант связан c клональной популяцией Т-клеток с аберрантным фенотипом. Метод полимеразной цепной реакции (ПЦР) показывает клональную перестановку генов рецепторов Т-клеток. У больных часто наблюдаются:
Ангионевротический отек, кожные нарушения, или оба признака
Циркулирующие иммунные комплексы (иногда с сывороточной болезни)
Гипергаммаглобулинемия (особенно высокие IgE)
Пациенты с лимфопролиферативным подтипом также восприимчивы к кортикостероидам, а иногда у них развивается Т-клеточная лимфома.
Гиперлейкоцитоз может возникать у пациентов с эозинофилическим лейкозом и большим количеством эозинофилов (например, > 100 000 клеток/мкл [> 100 × 10 9 /л]). Эозинофилы могут образовывать агрегаты, которые закупоривают мелкие кровеносные сосуды, что приводит к ишемии тканей и микроинфарктам. Общие проявления включают гипоксию мозга или легких (например, энцефалопатия, одышка или дыхательная недостаточность).
Идиопатическийдиопатический гиперэозинофильный синдром
Идиопатический гиперэозинофильный синдром встречается редко, имеет неизвестную частоту распространения и чаще всего поражает людей в возрасте от 20 до 50 лет. Только у некоторых больных с длительной эозинофилией Эозинофилия Эозинофилия – это увеличение числа эозинофилов в периферической крови >500/мкл (> 0,5 × 10 9 /л). Причины и сопутствующие заболевания являются многочисленными, но часто представляют. Прочитайте дополнительные сведенияОбщие справочные материалы
1. Apperley JF, Gardembas M, Melo JV, et al: Response to imatinib mesylate in patients with chronic myeloproliferative diseases with rearrangements of the platelet-derived growth factor receptor beta. N Engl J Med 347:481–487, 2002.
2. Shomali W, Gotlib J : World Health Organization-defined eosinophilic disorders: 2022 update on diagnosis, risk stratification, and management. Am J Hematol 97:129–148, 2022.
Симптомы и признаки гиперэозинофильного синдрома
Симптомы различаются и зависят от того, в каком органе возникло нарушение (см. таблицу Патологии у пациентов с гиперэозинофильным синдромом [Abnormalities in Patients With Hypereosinophilic Syndrome] Аномалии у больных с гиперэозинофильным синдромом ).
Иногда у больных с тяжелой формой эозинофилии (например, количеством эозинофилов > 100 000/мкл [> 100 × 10 9 /л]) развиваются такие осложнения гиперлейкоцитоза, как проявления гипоксии мозга или легких (например, энцефалопатия, одышка, дыхательная недостаточность). Также могут возникать и другие тромботические проявления (например, пристеночные тромбы сердца).
Диагностика гиперэозинофильного синдрома
Исключение вторичной эозинофилии
Тесты на определение поврежденного органа
Исследование костного мозга с цитогенетическим тестированием, если вторичные причины эозинофилии не выявлены
Обследование для выявления гиперэозинофильного синдрома должно быть проведено в случае, если уровень эозинофилов в периферической крови пациента > 1500/мкл (> 1,5 × 10 9 /л) больше чем в одном необъяснимом случае, особенно когда есть симптомы поражения органов. Должно быть проведено исследование для исключения заболеваний, вызывающих эозинофилию Обследование Эозинофилия – это увеличение числа эозинофилов в периферической крови >500/мкл (> 0,5 × 10 9 /л). Причины и сопутствующие заболевания являются многочисленными, но часто представляют. Прочитайте дополнительные сведенияОценка поражения органов должна включать биохимические анализы крови (включая уровень ферментов печени, креатинкиназы, определение почечной функции и уровня тропонина); ЭКГ; эхокардиографию; исследование функции легких и КТ органов грудной клетки, брюшной полости, и таза. Для выявления FIP1L1/PDGFRA-ассоциированного гибридного гена или других распространенных гибридных транскриптов и для оценки клональности Т-клеточного рецептора для исключения лимфоцитарного варианта гиперэозинофильного синдрома и других возможных причин эозинофилии выполняют аспирацию костного мозга и биопсию с проточной цитометрией, цитогенетическим тестированием и полимеразной цепной реакцией с обратной транскриптазой (отПЦР) или флуоресцентной гибридизацией in situ (FISH).
Прогноз при гиперэозинофильном синдроме
К смерти обычно приводят нарушения в органах, особенно в сердце. Поражение сердца не предсказывается степенью или длительностью эозинофилии. Прогноз варьируется в зависимости от реакции на терапию. Реакция на иматиниб дает лучший прогноз течения болезни среди пациентов со связанным с FIP1L1/PDGFRA гибридным геном и другими восприимчивыми гибридными генами.
Лечение гиперэозинофильного синдрома
Кортикостероиды для гиперэозинофилии и для продолжения лечения повреждений органов
Иматиниб для пациентов со связанным с FIP1L1/PDGFRA гибридным геном или другими сходными гибридными генами
Иногда применение препаратов для контроля содержание эозинофилов (например, гидроксимочевина, интерферон альфа, этопозид, кладрибин)
Лечение включает немедленную терапию, радикальную терапию (лечение, направленное на устранение самого заболевания) и поддерживающую терапию ( 1 Справочные материалы по лечению Гиперэозинофильный синдром является состоянием, которое характеризуется эозинофилией периферической крови с проявлениями поражения или дисфункции систем органов, обусловленных непосредственно. Прочитайте дополнительные сведения ). Не существует установленного уровня повышения количества эозинофилов, при котором происходит повреждение органа или когда должно быть начато лечение, однако большинство экспертов рекомендуют начинать лечение при абсолютном количестве эозинофилов от 1500 до 2000 эозинофилов/мкл (1,5–2 × 10 9 /L).
Немедленная терапия
Больным с очень тяжелой эозинофилией, осложнениями гиперлейкоцитоза или при обоих случаях одновременно (как правило, у пациентов с эозинофильным лейкозом) как можно скорее должны быть назначены высокие дозы кортикостероидов (например, преднизолон 1 мг/кг или его аналог). Если содержание эозинофилов намного ниже (например, на ≥ 50%) по истечении 24 часов, дозу кортикостероида можно повторять ежедневно. В противном случае начинают альтернативное лечение (например, гидроксимочвиной). Как только число эозинофилов начинает уменьшаться и лучше поддаваться контролю, можно начинать прием дополнительных препаратов.
Радикальная терапия
Пациентам без связанного с FIP1L1/PDGFRA гибридного гена, даже при бессимптомном течении, часто назначают одну дозу преднизона 60 мг (или 1 мг/кг) перорально, для определения восприимчивости к кортикостероидам (т.е., уменьшение уровня эозинофилов). У больных с симптомами или повреждениями органа, такую же дозу преднизолона продолжают давать один раз в день в течение 2 недель, после чего постепенно уменьшают дозу. Пациенты без симптомов и повреждения органов находятся под наблюдением в течение по крайней мере 6 месяцев для контроля за возможными осложнениями. Если употребление кортикостероидов не может быть легко снижено, то могут быть использованы кортикостероидо-щадящие препараты (например, гидроксимочевина, интерферон альфа).
Поддерживающая терапия
Поддерживающая лекарственная терапия и операция могут потребоваться при симптомах нарушений сердца (например, инфильтративная кардиомиопатия Обзор кардиомиопатий (Overview of Cardiomyopathies) Кардиомиопатии – это первичные заболевания сердечной мышцы. Их надо отличать от структурных заболеваний сердца, таких как ишемическая болезнь сердца, патология клапанного аппарата, врожденные. Прочитайте дополнительные сведения , поражения клапанов сердца Обзор нарушений клапанов сердца Патология любого клапана сердца может характеризоваться развитием стеноза или недостаточности (также называемой регургитацией или несостоятельностью), которые вызывают гемодинамические изменения. Прочитайте дополнительные сведения , сердечная недостаточность Сердечная недостаточность (СН) Сердечная недостаточность (СН) – синдром дисфункции желудочков сердца. Левожелудочковая недостаточность приводит к развитию одышки и быстрой утомляемости, правожелудочковая недостаточность –. Прочитайте дополнительные сведенияЭкспериментальные терапиии
Реслизумаб, моноклональное антитело к ИЛ5, которое применяется в лечении тяжелой бронхиальной астмы, проходит исследования при гиперэозинофилии, как и берализумаб, другое антитело к рецептору ИЛ5. В этой редкой популяции пациентов с гиперэозинофилией изучаются и новые ингибиторы FGFR1 (рецептора 1 фактора роста фибробластов). Ингибиторы JAK2 исследуются у пациентов с JAK2 перестройками.
Справочные материалы по лечению
1. Ogbogu PU, Bochener BS, Butterfield HJ, et al: Hypereosinophilic syndromes: A multicenter, retrospective analysis of clinical characteristics and response to therapy. J Allergy Clin Immunol 124:1319–1325, 2009.
2. Cortes J, Ault P, Koller C, et al: Efficacy of imatinib mesylate in the treatment of idiopathic hypereosinophilic syndrome. Blood 101:4714–4716, 2003.
3. Roufosse F, Kahn JE, Rothenberg FE, et al: Efficacy and safety of mepolizumab in hypereosinophilic syndrome: a phase III, randomized, placebo-controlled trial. J Allergy Clin Immunol 146: 1397–1405, 2020. doi: 10.1016/j.jaci.2020.08.037
4. Rothenberg ME, Klion AD, Roufosse FE, et al: Treatment of patients with the hypereosinophilic syndrome with mepolizumab . N Engl J Med 358:1215–28, 2008.
Основные положения
Гиперэозинофильный синдром является эозинофилией периферической крови ( > 1500/мкл [> 1,5 × 10 9 /л]) не вызванный паразитными, аллергическими, или другими вторичными причинами эозинофилии, которая длится ≥ 6 месяцев и вызывает или дисфункцию поражение органов.
По-видимому, гиперэозинофильный синдром является проявлением большого числа гематопоэтических нарушений, некоторые из которых имеют генетические причины.
Может быть поражен любой орган, но как правило, поражаются сердце, легкие, селезенка, кожа, и нервная система; поражение сердца может вызвать значительную заболеваемость и летальность.
Проводят анализы на вовлечение органов, включая ферменты печени; креатинкиназу и уровни креатинина и тропонина; ЭКГ и эхокардиографию; исследования функции легких; и КТ груди, брюшной полости, и таза.
Для выявления причины выполняют исследование костного мозга с цитогенетическим анализом.
При тяжелой эозинофилии и/или повреждения органаов назначают кортикостероиды. Ингибиторы тирозинкиназы, такие как низкие дозы иматиниба, могут оказывать благоприятное действие при подтипах, связанных с явными хромосомными расстройствами.
Авторское право © 2022 Merck & Co., Inc., Rahway, NJ, США и ее аффилированные лица. Все права сохранены.
Эндокардит Леффлера ( Эозинофильный эндокардит )
Эндокардит Леффлера – это редкая форма рестриктивной кардиомиопатии с поражением оболочек сердца в результате их инфильтрации эозинофилами. Симптомы включают лихорадку, потерю веса, кардиалгию, одышку и другие проявления сердечной недостаточности. В дальнейшем возникают признаки тромботических поражений печени, селезенки, легких. Диагностика производится посредством лабораторных анализов, исследования работы сердца (ЭКГ, ЭхоКГ), допплерографии и рентгенографии органов грудной клетки. Лечение предполагает устранение причин гиперэозинофильного синдрома, терапию сердечной недостаточности и профилактику тромбозов. В ряде случаев назначается хирургическое вмешательство.
МКБ-10
Общие сведения
Эндокардит Леффлера (эозинофильный эндокардит) был описан в 1936 году швейцарским врачом Вильгельмом Леффлером при наблюдении двух больных с быстро прогрессирующей сердечной недостаточностью. В настоящее время данная патология считается клиническим вариантом гиперэозинофильного синдрома с преимущественным поражением сердечно-сосудистой системы.
Чаще всего заболевание регистрируется у мужчин средней (30-40 лет) возрастной группы, но может возникать у лиц любого возраста и пола при высоком количестве эозинофилов в крови. Частота встречаемости выше у людей негроидной расы, жителей Юго-Восточной Азии и Южной Америки. Такое региональное распределение совпадает с распространенностью генетически обусловленного идиопатического гиперэозинофильного синдрома (ГЭС).
Причины
Главным этиологическим фактором заболевания выступает выраженное увеличение уровня эозинофилов в периферической крови. В результате создаются условия для инфильтрации данными клетками миокарда и эндокарда с развитием специфического воспаления. Достоверно выяснено, что именно появление эозинофилии предшествует возникновению сердечно-сосудистых нарушений. Причинами повышенного образования эозинофилов могут быть различные факторы и патологические состояния:
- Идиопатический гиперэозинофильный синдром. Редкое состояние неясной этиологии, проявляющееся пролиферацией эозинофильных гранулоцитов в костном мозге. Предположительно обусловлено мутациями – делецией 4-й хромосомы в области гена FIP1L1/PDGFRA, отвечающего за контроль гемопоэза. Характеризуется продолжительной выраженной эозинофилией, сопровождается высоким риском развития лейкоза.
- Аутоиммунные заболевания. Некоторые патологии (системная красная волчанка, ревматоидный артрит) могут осложняться появлением вторичных форм ГЭС. Последний провоцирует поражение оболочек сердца по типу эндокардита Леффлера.
- Аллергические и паразитарные болезни. При этих состояниях всегда наблюдается рост уровня эозинофилов. Крайне редко их количество достигает уровня, достаточного для инфильтрации миокарда или эндокарда. В основном такой вариант патологии обнаруживается у детей с высокой реактивностью иммунной системы.
- Онкологические заболевания. Эозинофильный лейкоз и другие опухолевые процессы кроветворной системы характеризуются быстрым активным делением слабо дифференцированных клеток. Их большое количество наряду с облегченным проникновением в ткани (в том числе сердца) способно провоцировать воспаление эндокарда.
Развитие эозинофильного эндокардита описано и при других состояниях, сопровождающихся повышенным образованием данных клеток: синдроме Глейча, поражениях селезенки, костного мозга. Установлено, что только наличия большого количества эозинофилов недостаточно для возникновения заболевания. Необходимым условием является их активация с выделением содержимого гранул – поражение сердца возникает при дегрануляции не менее 15% от объема циркулирующих клеток. Это объясняет то обстоятельство, почему в разных случаях при примерно равном количестве гранулоцитов выраженность эндокардита может сильно отличаться.
Патогенез
Ввиду редкости эндокардита Леффлера патогенез этого состояния изучен недостаточно. Понимание некоторых этапов заболевания строится не на клинических и исследовательских данных, а на общем видении иммунологических процессов. При наличии в крови большого количества активированных эозинофилов некоторые из них проникают в ткани сердца.
В процессе дегрануляции они выделяют катионные белки и стимуляторы воспаления, приводя к повреждению клеток. Кроме того, данные протеины обладают способностью запускать процесс коагуляции, тем самым провоцируя внутрисосудистое тромбообразование. Это обстоятельство в сочетании с изменением эндометрия ведет к развитию пристеночных тромбов внутри камер сердца. Их фрагменты в виде эмболов разносятся с током крови, вызывая инфаркты в почках, селезенке, головном мозге.
Отек, дистрофия структур эндокарда и миокарда способствуют разрастанию соединительной ткани, деформирующей хорды, а в дальнейшем и клапаны сердца. Все это, наряду с уменьшением количества кардиомиоцитов, приводит к снижению объема выброса, регургитации крови и возникновению сердечной недостаточности. Ослабленная работа сердца становится причиной многочисленных вторичных нарушений – отека легких, дистрофии печени, гипоксии. Без лечения больные эндокардитом Леффлера могут умереть от ХСН или осложнений, вызванных тромбоэмболией сосудов жизненно важных органов (легких, мозга, почек).
Симптомы эндокардита Леффлера
Клиническая картина патологии характеризуется выраженной стадийностью, длительность каждого этапа заболевания индивидуальна у разных больных и колеблется от 2-3 недель до нескольких месяцев. Первоначально у пациентов возникают жалобы на повышенную температуру тела, боли в области печени, потливость, слабость. Эти проявления соответствуют гиперэозинофильному синдрому и предшествуют поражению сердца. В некоторых случаях у больных имеются симптомы СКВ, ревматоидного артрита, бронхиальной астмы и других состояний, способных спровоцировать пролиферацию эозинофилов.
- Первая стадия эндокардита Леффлера (некротическая) у 20% пациентов характеризуется усилением симптомов ГЭС – перемежающейся лихорадки, гипергидроза, развитием отеков. Для такого варианта патологии характерны жалобы на боли в груди различной локализации, нарушение аппетита, потерю массы тела вплоть до анорексии. Примерно у половины больных первая стадия эозинофильного воспаления сердца протекает по типу острого кардита. В такой ситуации рано развиваются признаки бивентрикулярной недостаточности – одышка, слабость, кашель в результате застоя крови в легких. Возникает ретинопатия со снижением остроты зрения, появлением «мушек» и «вспышек» перед глазами, головными болями.
- Вторая стадия эндокардита называется тромботической – для нее характерно образование пристеночных тромбов в желудочках сердца. Оттуда их фрагменты разносятся по всему организму, нарушая кровоснабжение различных органов. Частыми симптомами являются неврологическая дисфункция (парезы, параличи) и поражение почек – снижение диуреза, боли в пояснице, гематурия. Возможно развитие симптоматики инфаркта легкого, селезенки, печени. На данном этапе у части больных возникают наиболее тяжелые осложнения эндокардита Леффлера – инсульты, тромбоэмболия магистральных артерий.
- Конечной стадией заболевания является фибротическая, проявляющаяся выраженной рестриктивной кардиомиопатией. На первый план выступают признаки нарастающей сердечной недостаточности – отеки, затруднение дыхания из-за наличия жидкости в легких, цианоз кожи. Со временем к симптомам присоединяется увеличение живота из-за асцита, кровохарканье, резкое ухудшение общего состояния по причине метаболических нарушений. Недостаточность обычно носит бивентрикулярный характер, поэтому проявляется застоем крови как в малом, так и в большом круге кровообращения.
Осложнения
Эндокардит Леффлера способен вызывать ряд тяжелых осложнений, которые создают угрозу жизни больного. На начальных этапах заболевания, протекающих по типу кардита, может развиваться острая сердечная недостаточность из-за поражения миокарда и уменьшения его сократительной функции. Особенно опасна тромбоэмболия – значительная часть летальных исходов при эндокардите возникает по причине ишемических нарушений в органах (почках, головном мозге, структурах ЖКТ).
У лиц с идиопатическим ГЭС существует риск появления онкологической патологии – лейкоза или лимфомы. При отсутствии лечения и развитии терминальной фибротической стадии заболевания смерть наступает из-за полиорганной недостаточности в результате резко сниженной функции сердца.
Диагностика
Диагностика эндокардита Леффлера осуществляется врачом-кардиологом, который ввиду сложной этиологии состояния должен кооперироваться с иммунологами, ревматологами или онкологами. Важно доказать взаимосвязь между высоким уровнем эозинофилов и сердечно-сосудистыми симптомами, поскольку это влияет на лечение и прогноз. Клиническая картина и результаты диагностических исследований могут изменяться на различных этапах развития патологии, что также следует учитывать при определении заболевания. Для выявления и подтверждения наличия эозинофильного эндокардита используют следующие методики:
- Опрос и общий осмотр. На некротической стадии проявлениями заболевания выступают жалобы на боль в груди, сильное похудение, кашель, периодическое повышение температуры тела. При прогрессировании болезни осмотр позволяет обнаружить неврологические расстройства, увеличение размеров печени и селезенки, асцит. При аускультации сердца обнаруживаются нарушения ритма, сторонние шумы (например, шум митральной недостаточности).
- Рентгенография. У большинства больных на рентгенограмме грудной клетки определяется кардиомегалия, выраженность которой зависит от стадии заболевания. Застой в малом круге кровообращения на фоне ХСН проявляется увеличением тени корней легкого и усилением легочного рисунка.
- Ультразвуковые исследования.ЭхоКГ выявляет утолщение в области верхушки сердца, которое ассоциируется с фиброзным процессом или тромботическими отложениями. Исследование подтверждает утолщение и деформацию хорд, створок клапанов (главным образом, трикуспидального и митрального). Ультразвуковая допплерография сердца определяет нарушение гемодинамики в камерах органов – вентрикулоатриальную регургитацию крови.
- Электрокардиография. На ЭКГ имеются изменения ST-сегмента, расширение зубца Т и нерегулярный сердечный ритм. По мере прогрессирования кардиомегалии возникает отклонение электрической оси сердца влево. Нередко выявляется блокада одной из ножек пучка Гисса.
- Лабораторные анализы. Общий анализ крови подтверждает высокое количество эозинофилов и неспецифические признаки воспаления – увеличение СОЭ, лейкоцитоз. Иногда обнаруживаются слабо дифференцированные гранулоциты, что свидетельствует о неопластическом процессе в кроветворной системе. Биохимическое исследование крови свидетельствует о росте уровня АсАТ и белков плазмы.
В рамках дополнительной диагностики может назначаться обследование органов выделения, МРТ головного мозга, МСКТ сердца, легких, печени и брюшной полости. Они используются для выявления осложнений, обусловленных эндокардитом Леффлера, а также для определения возможных причин ГЭС. Дифференциальную диагностику проводят с другими воспалительными поражениями сердца (бактериальными или вирусными эндокардитами, миокардитами и перикардитами). Необходимо выяснить происхождение эозинофилии, что важно для дальнейшего лечения патологии.
Лечение эндокардита Леффлера
При подтвержденном диагнозе эозинофильного эндокардита назначается сложное многокомпонентное лечение. Оно не ограничивается только мероприятиями в сфере терапевтической кардиологии, важно устранить главный этиологический фактор – гиперэозинофильный синдром. Нужно минимизировать риск осложнений со стороны других органов, возникающих вследствие тромбоза и сердечной недостаточности. Каждое направление лечения подразумевает использование особых лекарственных средств и терапевтических мероприятий. Отдельным методом является хирургическое вмешательство, направленное на устранение последствий склеротических процессов в эндокарде. Все лечебные процедуры при эндокардите Леффлера разделяют на следующие группы:
- Устранение причины ГЭС. Относится к этиотропному лечению, поскольку направлено против главного фактора заболевания – эозинофилии крови. Идиопатические и неопластические варианты ГЭС лечат посредством использования иматиниба (ингибитор тирозинкиназы) и цитостатических средств. Высокий уровень эозинофилов аллергического или аутоиммунного генеза корригируют назначением кортикостероидов.
- Терапия сердечной недостаточности. Является базовым методом консервативного лечения. Применяют сердечные гликозиды, бета-адреноблокаторы, ингибиторы АПФ и другие традиционные средства. При развитии застойных явлений и отеков назначают петлевые диуретики при условии контроля за кислотно-щелочным и электролитным равновесием крови.
- Профилактика осложнений. Главной угрозой при данной патологии является тромбообразование с последующей эмболией сосудов различных органов. Для снижения скорости внутрисосудистого свертывания крови используют низкомолекулярный гепарин и иные антикоагулянты.
- Хирургическое лечение. В тяжелых случаях при возникновении рестриктивной ХСН показано оперативное вмешательство – эндокардэктомия (декортикация сердца). Кардиохирург удаляет фиброзные разрастания в камерах органа, производит пластику атриовентрикулярных клапанов и хорд. Эндокардэктомия считается очень сложной операцией с относительно высокой смертностью, выполняется лишь в специализированных кардиохирургических центрах.
Больному показана госпитализация в кардиологическое отделение и строгий постельный режим. Дополнительные лечебные мероприятия назначаются при наличии показаний. Тромбоэмболии некоторых органов (кишечника, селезенки, почек) могут быть основанием для проведения хирургических операций. При развитии ХСН требуется инфузионная терапия для устранения метаболического ацидоза и электролитных нарушений.
Прогноз и профилактика
Прогноз эндокардита Леффлера зависит от этиологии гиперэозинофильного синдрома и его реакции на лечебные мероприятия. При ГЭС невыясненного генеза перспективы лечения неопределенные, даже использование значительных доз кортикостероидов лишь несколько снижает уровень эозинофилов – при этом смертность от патологии остается высокой. Однако часто специалистам удается выяснить причины эозинофилии и разработать этиотропную терапию, что значительно повышает выживаемость больных.
Специфической профилактики не существует. При выявлении повышенного количества эозинофильных гранулоцитов рекомендуется производить периодический мониторинг картины крови. При сохранении такого состояния более месяца и исключении его очевидных причин (паразитарные и аллергические болезни) следует обратиться к гематологу.
2. Редкий клинический случай париетальный эндокардит Леффлера (эозинофильный эндомиокардит) в кардиологическом отделении республиканской клинической больницы/ Содномова Л.Б. Шпак И.А. Эрдынеева Э.Б.// Acta Biomedica Scientifica. - 2009.
Эндокардит Леффлера с поражением обоих желудочков

Фибропластический париетальный эндокардит, или эндокардит Леффлера (Loeffler) – редко встречающееся приобретенное заболевание эндокарда и миокарда, которое характеризуется резким снижением податливости одного или обоих желудочков с резким нарушением его/их диастолической функции и массивным пристеночным тромбообразованием. На сегодняшний день существует несколько классификаций заболеваний, куда включен эндокардит Леффлера. Согласно современной классификации кардиомиопатий (2008) данное заболевание относится к вторичным рестриктивным кардиомиопатиям (РКМП), развившимся в результате таких системных заболеваний, как амилоидоз, саркоидоз, карциноидная болезнь, склеродермия, антрациклиновая КМП, фиброэластоз и др. [1].
С другой стороны, на сегодняшний день эндокардит Леффлера рассматривают как проявление гиперэозинофильного синдрома (ГЭС), протекающего с преимущественным поражением сердца [2]. Гиперэозинофильный синдром включает две клинические формы: синдром Леффлера І (летучие эозинофильные инфильтраты в легких) и синдром Леффлера ІІ (эндокардит Леффлера). Поражение сердца – основная причина осложнений и летальных исходов при ГЭС.
Крайне редко подобное поражение сердца бывает изолированным (только сердце) и первичным (скорее, идиопатическим). По гемодинамике эндокардит Леффлера – классическая рестриктивная кардиомиопатия, по патогенезу – следствие гиперэозинофилии.
Связь между эозинофилией, активной фазой миокардита и полиорганной недостаточностью впервые была установлена Леффлером в 1936 г. При данной патологии выявляется эозинофильный эндомиокардит с тенденцией к фиброзированию, что клинически проявляется прогрессирующей сердечной недостаточностью (СН) и тромбоэмболическими осложнениями.
Эозинофильный эндокардит хорошо освещен в литературе, однако прижизненная диагностика повреждения миокарда и сосудов вследствие эозинофильной инфильтрации и их обильной дегрануляции встречается редко [3]. Причиной поздней диагностики в большинстве случаев является быстрое развитие эозинофильных артериитов и миокардитов [4, 5]. Вовлечение в патологический процесс миокарда указывает на острую некротическую фазу эозинофильного эндомиокардита [6, 7]. Токсическое повреждение органов обусловлено содержимым внутриклеточных гранул эозинофилов [8, 9]. Морфологические аномалии эозинофилов выражаются в преобладании зрелых активных форм. Они развиваются из стволовой клетки-предшественницы костного мозга и содержат целый ряд Т-клеточных цитокинов, ростовые факторы, включая интерлейкины 3, 5, а также гранулоцитарный моноцитарный колониестимулирующий фактор. Цитокины и ростовые факторы индуцируют повреждение органа-мишени путем стимулирования секреции воспалительных медиаторов, что приводит к повреждению ткани, ремоделированию и фиброзу. Кроме того, катионы эозинофильных белков связываются с анионами эндотелиальных белков (тромбомодулинами). Образующийся комплекс белков ухудшает антикоагулянтную активность и приводит к повышенному тромбообразованию [10, 11]. Интенсивность и острота активной фазы эозинофильного эндокардита тесно связана с количеством циркулирующих эозинофилов и длительностью предшествующей эозинофилии [12].
Типичные клинические симптомы эндокардита Леффлера – потеря массы тела, лихорадка, кашель, сыпь и нарастающая ХСН. Несмотря на то что поражение сердца вначале может протекать бессимптомно, у 50% пациентов одышка появляется уже на ранних этапах заболевания.
При рентгенологическом обследовании органов грудной клетки обнаруживают кардиомегалию и признаки венозного застоя в легких. Изменения ЭКГ не специфичны. Частые находки – нарушения ритма сердца, особенно фибрилляция предсердий (ФП). В диагностике заболевания основную роль играет эхокардиография (ЭхоКГ), позволяющая обнаружить локальное (реже – диффузное) утолщение верхушки одного или обоих желудочков с вовлечением в патологический процесс хорд, умеренную митральную или трикуспидальную регургитацию, пристеночные, особенно верхушечный, крупные тромбы. Показательным является «рестриктивный тип» ремоделирования сердца и внутрисердечной гемодинамики – очевидное преобладание объема предсердий над объемами желудочков. Систолическая функция, как правило, сохранена, но диагностируется диастолическая дисфункция – рестриктивный тип трансмитрального/транстрикуспидального кровотока. Наиболее информативными методами исследования на сегодняшний день являются магнитно-резонансная томография (МРТ) и мультиспектральная компьютерная томография с контрастированием 14. В литературе описан случай динамического наблюдения за развитием эндокардита Леффлера с серией одновременно производимой позитронно-эмиссионной томографии и контрастированной МРТ с выделением стадий: бессимптомной, острой некротической, симптомной тромботической и фибротической [13]. Выполнение эндомиокардиальной биопсии миокарда правого (ПЖ) или левого (ЛЖ) желудочка позволяет подтвердить или опровергнуть диагноз эндокардита Леффлера.
Прогноз при классическом эндокардите Леффлера неблагоприятный. Большинство пациентов умирают в течение 6-12 мес от манифестации СН (а не от постановки диагноза). Смерть обычно наступает вследствие хронической СН (ХСН) и полиорганной недостаточности. К сожалению, в подавляющем большинстве случаев до сих пор не удается установить причины возникновения гиперэозинофилии или выявление причинного фактора уже не влияет на прогноз. Именно поэтому клинический исход заболевания часто неблагоприятный, несмотря на то что назначение преимущественно глюкокортикоидов и некоторых противоопухолевых препаратов может уменьшить гиперэозинофилию.
Клинический случай
Пациентка О., 39 лет (рост 161 см, вес 62 кг), в течение полугода наблюдалась у семейного врача с жалобами на одышку от легкой до умеренной, возникающую при физической нагрузке, выраженную метеочувствительность, слабость, эпизоды сердцебиения, перебои в работе сердца. Согласно записям в амбулаторной карте уровень артериального давления (АД) варьировал от 80/50 до 110/80 мм рт. ст.

Рис. 1. Синусовая тахикардия. Желудочковые экстрасистолы (ЭС). Отклонение электрической оси сердца вправо. Отсутствие амплитудной динамики низковольтного зубца R в грудных отведениях

Рис. 2. Неравномерное значительное утолщение стенок ПЖ (парастернальный доступ, позиция по длинной оси)

Рис. 3. Тромб у верхушки ПЖ, уплотнение между листками перикарда в области верхушки (четырехкамерная позиция сердца)

Рис. 4. Сохраненная кинетика стенок ЛЖ, гидроперикард по ЗСЛЖ (парастернальный доступ, позиция по длинной оси, М-режим)

Рис. 5. Рестриктивный транстрикуспидальный кровоток (допплер)
УЗИ органов брюшной полости: эхопризнаки гепатоспленомегалии, диффузные изменения в поджелудочной железе, отек стенок желчного пузыря, выпот в обеих плевральных полостях (синусы).
Лечение – метилпреднизолон 500 мг 2 раза в сутки 5 дней, далее преднизолон 30 мг/сут, иматиниб 100 мг по 4 табл./сут (400 мг), ивабрадин 5 мг 2 раза в сутки, спиронолактон 100 мг/сут, торасемид 10 мг/сут, силденафил 25 мг 2 раза в сутки, надропарин 0,4 мл 2 раза в сутки внутримышечно, омепразол 40 мг/сут.
Через 4 дня лечения состояние пациентки заметно улучшилось, основным признаком улучшения стало уменьшение одышки. Повторные ЭхоКГ очевидной динамики не выявили.
14.04.2015 г. пациентка была госпитализирована в Национальный научный центр «Институт кардиологии им. Н.Д. Стражеско» в отделение некоронарогенных заболеваний сердца и клинической ревматологии, где был выставлен (подтвержден и уточнен) диагноз: ГЭС. Эндокардит Леффлера с поражением ЛЖ и ПЖ. Массивные пристеночные тромботические наслоения в ПЖ. Апикальный тромб ЛЖ. Мелкие тромбы в ушках обоих предсердий. Синусовая тахикардия. Единичные желудочковые ЭС. Перикардит с небольшим количеством жидкости. СН IIА ст. со сниженной сократительной функцией ЛЖ ІІ ФК по NYHA. Аутоиммунный тиреоидит, эутиреоз. Токсокароз, висцеральная фаза.
Рис. 6. Нарастание низковольтности ЭКГ в динамике (в сравнении с ЭКГ от 2012 г., рис. 1)
ЭКГ, представленная на рисунке 6, демонстрирует нарастание низковольтности ЭКГ в динамике (в сравнении с ЭКГ от 2012 г., рис. 1).
ЭхоКГ: Патологические изменения миокарда ПЖ с утолщением стенок до 18 мм. Диффузный гипокинез стенок ЛЖ с дискинезом верхушки – ФВ 44%. В области верхушки ПЖ – наслоения между листками перикарда. Небольшое количество жидкости в полости перикарда – по ЗСЛЖ до 5 мм. Таким образом, в динамике на ЭхоКГ наблюдалось снижение сократительной функции ЛЖ на фоне его гипертрофии и, несмотря на проведенную высокодозовую терапию гормонами, не уменьшилась гипертрофия ПЖ.

Рис. 7. Динамическая томография, боковая проекция с контрастированием эндокарда (1) и тромба ПЖ (2)

Рис. 8. Динамическая томография, поперечная проекция с контрастированием полостей и тромба в ПЖ (1), гидроперикарда по всем стенкам (2)

Рис. 9. Динамическая томография, поперечная проекция с контрастированными полостями и стенками – неравномерное утолщение миокарда желудочков (1) с двумя апикальными тромбами (2)

Рис. 10. Динамическая томография, боковая проекция с контрастированием полостей и стенок – апикальный тромб ЛЖ

Рис. 11. Динамическая томография, косая проекция с контрастированием полостей и стенок – апикальные тромбы ЛЖ
В ходе серии динамических МРТ с контрастированием (рис. 7-11) выявлены массивные пристеночные тромботические наслоения в ПЖ, апикальный тромб ЛЖ.
С учетом наличия и стойкости в динамике гиперэозинофилии у пациентки были взяты анализы крови для определения наличия антител IgG к гельминтам и выявлены хронический токсокароз и аскаридоз (табл. 1).
Количественный анализ показал четырехкратное увеличение титра антител IgG к токсокаре (табл. 2), что было расценено как причина ГЭС. Трехкратное увеличение концентрации IgЕ в сыворотке крови косвенно подтвердило хроническую глистную инвазию (табл. 3).
СТАТТІ ЗА ТЕМОЮ Кардіологія
Сьогодні в рамках оцінки чинників ризику серцево-судинних (СС) захворювань дедалі більший інтерес наукового світу прикутий до ендотелію та його функції. Ендотелій уражається насамперед унаслідок артеріальної гіпертензії (АГ), це проявляється розвитком його дисфункції та морфологічною перебудовою артеріальної стінки. Добре відомо, що з віком підвищується судинна жорсткість, що пов’язують зі зниженням в артеріальній стінці вмісту еластину та підвищенням кількості колагену 3. У разі АГ перебіг цих процесів значно прискорюється – судинний вік починає випереджати хронологічний (паспортний). Тому дедалі більше науковців для опису функціонального та морфологічного стану серцево-судинної системи використовують термін «синдром раннього старіння судин», або EVA‑синдром (early vascular aging), як модель старіння судин, яка більш точно відображає структурні та функціональні зміни, що відбуваються в організмі в міру його старіння [1].
Ішемічна хвороба серця (ІХС) є провідною причиною інвалідизації та смертності від серцево‑судинних захворювань (ССЗ). У розвинених країнах Європи на 1 млн населення припадає 30-40 тис. хворих, які страждають на ІХС [1]. До того ж немає пояснень для показників смертності українських чоловіків і жінок, які в 14 і 23 рази більше, ніж у Франції [2]. Крім базисної терапії пацієнтів з ІХС, потенційним напрямом лікування є застосування підходів, які здатні покращити енергозабезпечення кардіоміоцитів, мікроциркуляцію та функцію ендотелію судин [3].
COVID‑19 чинить суттєвий негативний вплив на серцево-судинну (СС) систему. Наявні у пацієнтів серцево-судинні захворювання (ССЗ) до інфікування COVID‑19 та вірусне навантаження асоційовані з пошкодженням міокарда й гіршими результатами. Пандемія триває, зокрема, з’являються нові варіанти коронавірусу, тож розуміння патофізіології та відповідних клінічних наслідків допоможе розширити уявлення про основні механізми розвитку хвороби. Вирішальне значення також мають встановлення нових біомаркерів СС-ускладнень і розробка ефективних методів лікування COVID‑19. Пропонуємо до вашої уваги консенсусний документ Європейського товариства кардіологів (ESC) та Асоціації невідкладної кардіологічної допомоги (ACVC) у співпраці з Європейською асоціацією серцевого ритму (EHRA) 2021 р., у якому підсумовано сучасні відомості про ураження СС-системи на тлі COVID‑19 та його постгострі наслідки. .
Незважаючи на сучасні методи відновлення коронарного кровотоку, показники смертності після перенесеного гострого коронарного синдрому (ГКС) залишаються досить високими, що пов’язують з ушкодженням міокарда під час реперфузії. Відповідно до сучасних уявлень, провідною причиною цього явища є ішемічний каскад, який може запускати процеси загибелі кардіоміоцитів і бути відповідальним за 50% кінцевого розміру зони некрозу при ГКС, виникнення реперфузійних аритмій, систолічної мікросудинної дисфункції. Саме тому адекватне блокування ішемічного каскаду, спрямоване на елімінацію активних форм кисню, активацію антиоксидантів, на сьогодні вважається важливою складовою менеджменту пацієнтів із ГКС. .
Читайте также: